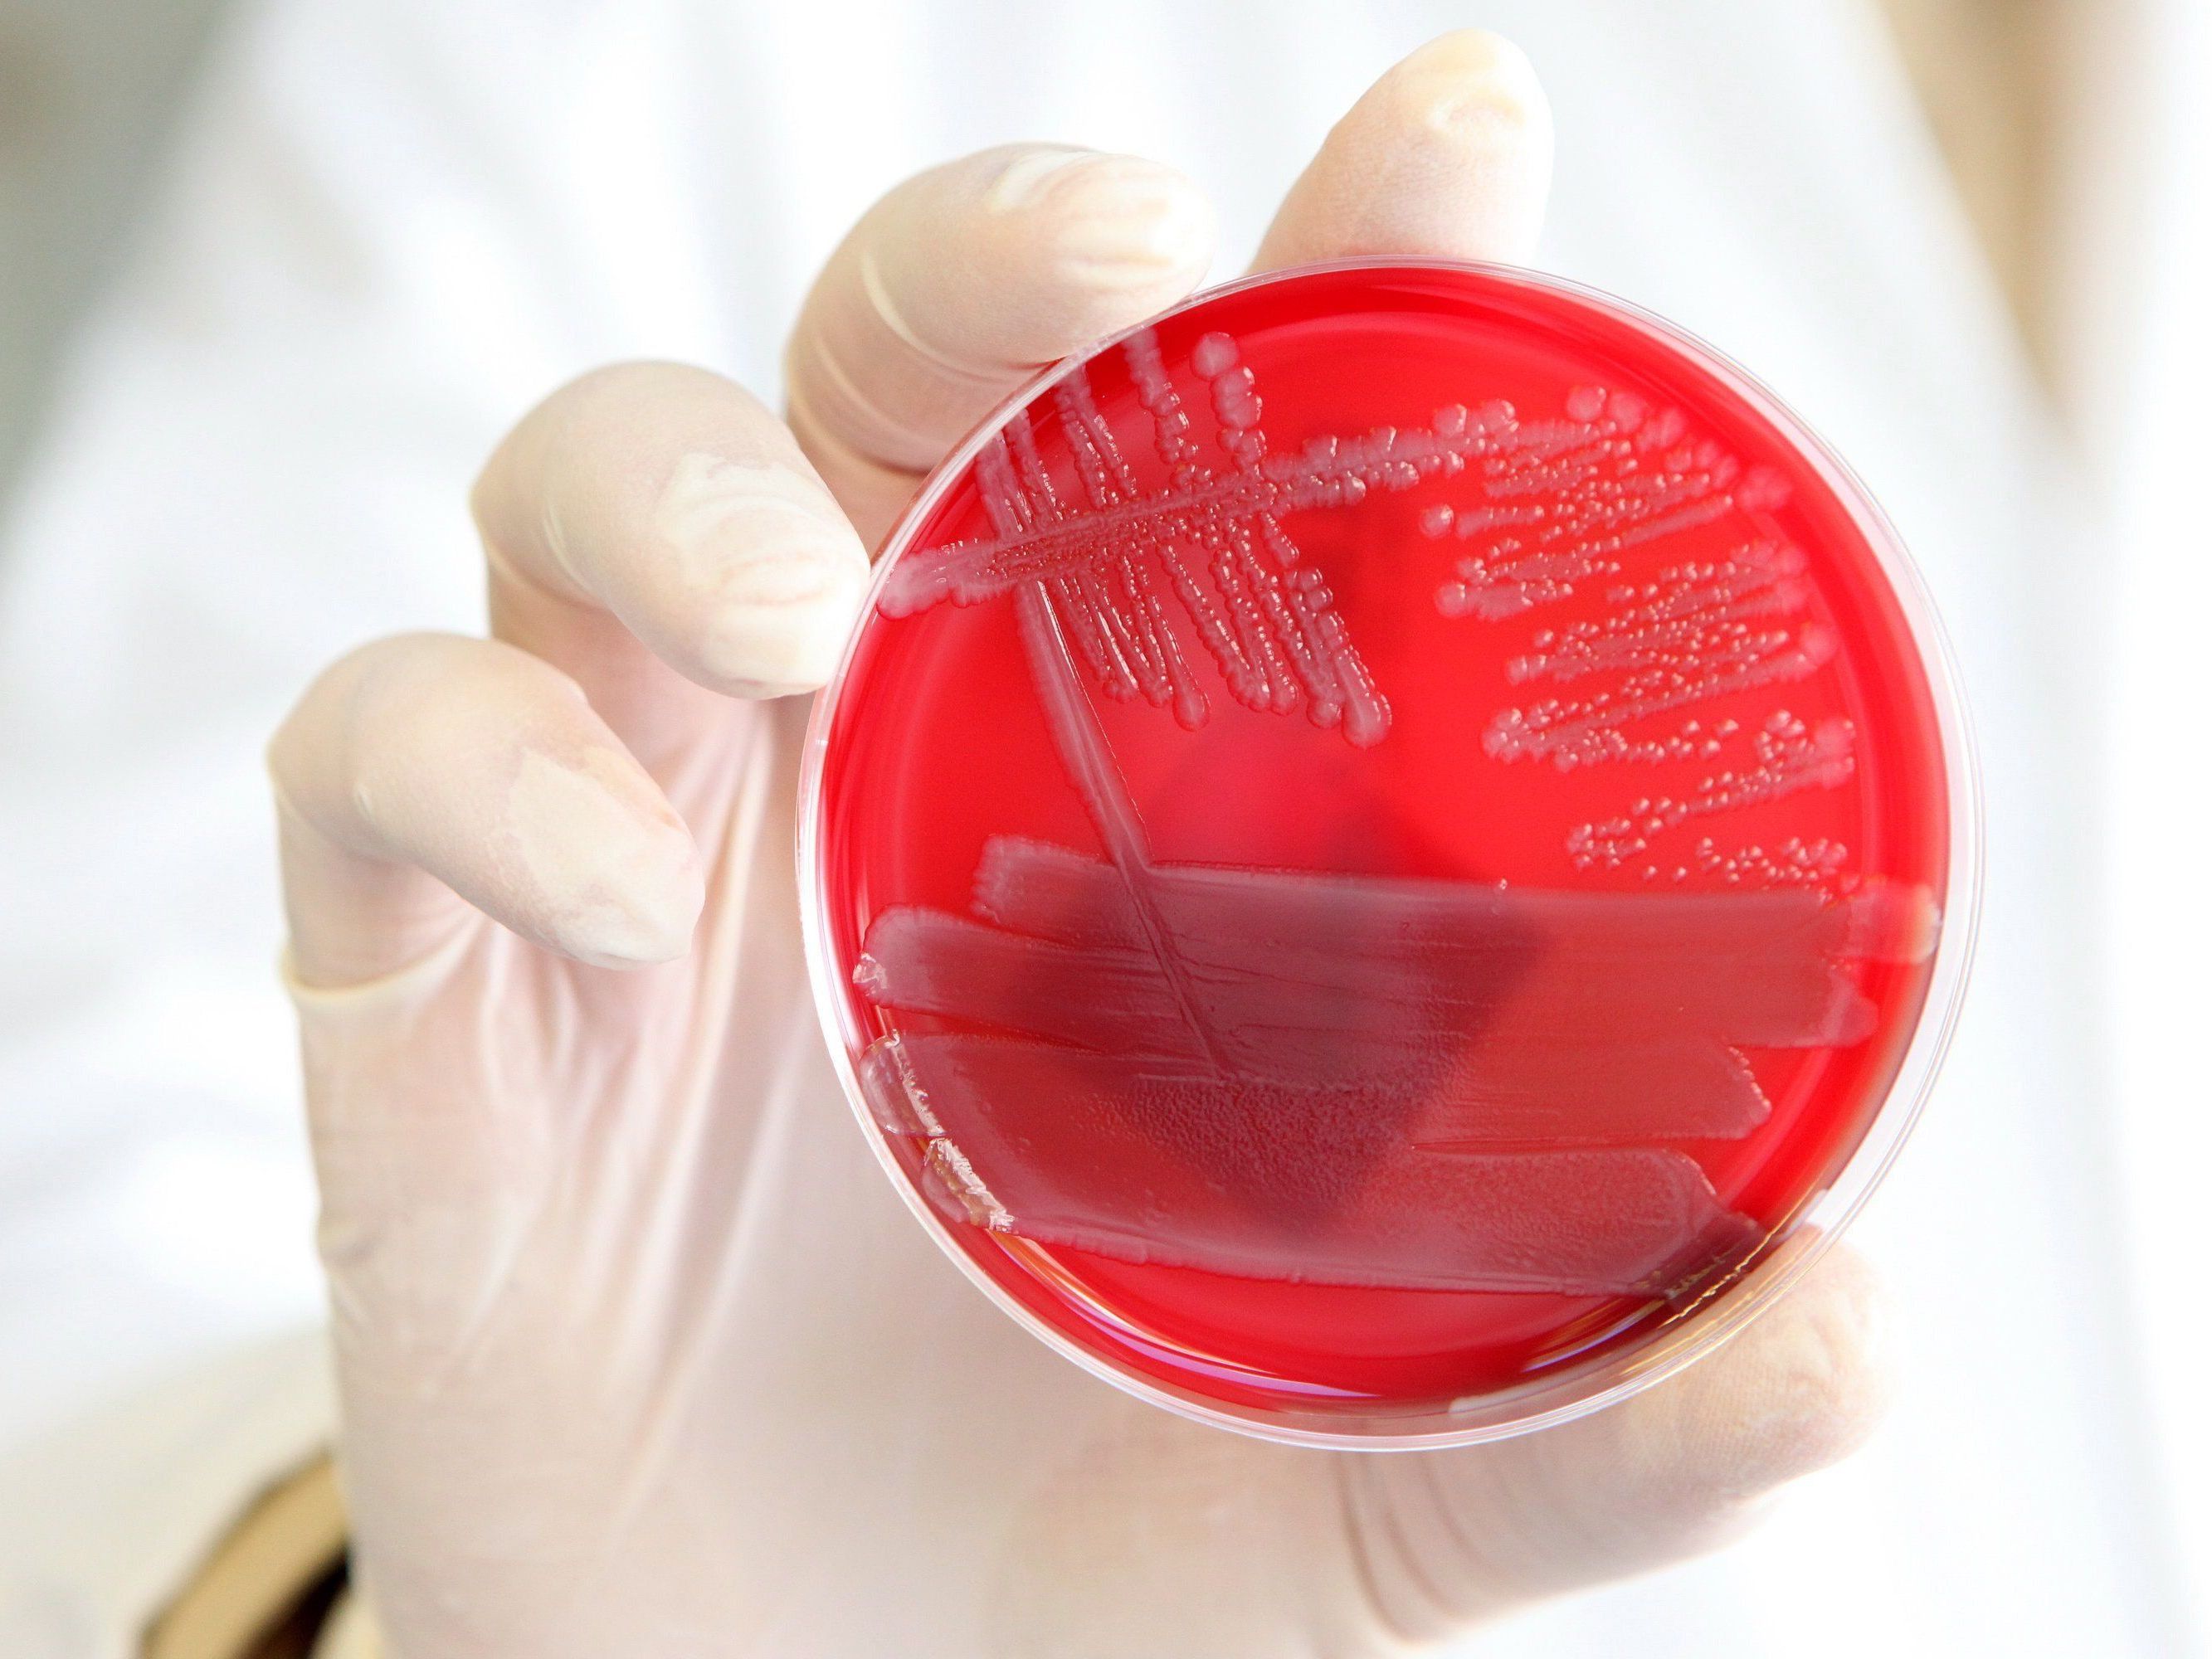

Lidl ruft Salmonellen verseuchtes Tiefkühlgericht zurück
Im Zuge von internen Qualitätskontrollen wurde bei einer Probe des oben genannten Artikels des deutschen Herstellers SK-Meat Vertriebs GmbH Salmonella typhimurium nachgewiesen. Bei Einhaltung der auf der Verpackung angebrachten Küchenhygiene- und Durcherhitzungshinweise besteht üblicherweise keine Gefahr für Konsumenten.
Rückruf wegen Salmonellen
Trotzdem hat Lidl Österreich nach Bekanntwerden des Untersuchungsergebnisses vorsorglich sämtliche Produktionschargen des betroffenen Artikels österreichweit aus dem Verkauf genommen. Lidl Österreich bittet alle Kunden, bereits gekaufte Artikel in den Lidl-Filialen zurückzugeben. Der Kaufpreis wird auch ohne Kaufbeleg rückerstattet. Der Konzern betreibt 200 Filialen, der Hauptsitz des Unternehmens befindet sich in Salzburg.
Was sind Salmonellen?
Salmonellen sind Bakterien. Durch Salmonellen verursachte Infektionen (Salmonellosen) zählen weltweit zu den häufigsten bakteriellen Durchfallserkrankungen. Die Übertragung der Salmonellen erfolgt hauptsächlich durch den Verzehr roher oder ungenügend erhitzter Lebensmittel tierischer Herkunft (Eier, Geflügel, Fleisch und Milch). Die Symptome (Übelkeit, Durchfall, Erbrechen, Fieber, Kreislaufbeschwerden, Bauchkrämpfe) dauern in der Regel nur wenige Stunden oder Tage an. Besonders gefährdet sind neben älteren Personen vor allem Kleinkinder, Schwangere und Menschen mit einem geschwächten Immunsystem. Durch Hitzeeinwirkung sterben Salmonellen bei 55 Grad Celsius nach einer Stunde, bei 60 Grad Celsius nach einer halben Stunde ab. Als gesicherte Keimabtötung gilt ein Erhitzen auf über 70 Grad für mindestens 15 Sekunden.
(Quelle: Ages)





